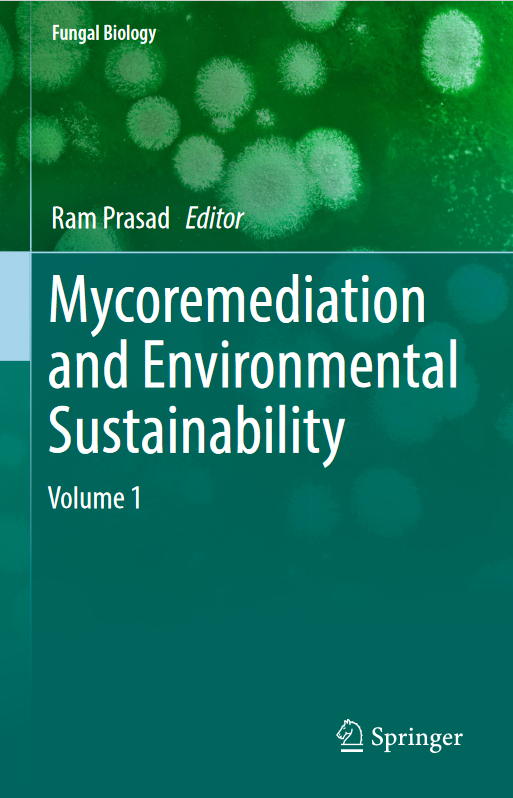
Book cover of Mycoremediation and Environmental Sustainability: Volume 1 by Ram Prasad Book cover of Mycoremediation and Environmental Sustainability: Volume 1 by Ram Prasad

Newly released
This book is new and will be uploaded as soon as it becomes available to us and if we secure the necessary publishing rights.
Mycoremediation and Environmental Sustainability: Volume 1 PDF - Ram Prasad
Ram Prasad • Biology • 243 Pages
(0)
Quate
Review
Save
Share
Book Description
Bioremediation is the use of microorganisms' metabolism to degrade waste contaminants (sewage, domestic, and industrial effluents) into non-toxic or less toxic materials by natural biological processes. Remediation through fungi—or mycoremediation—has multifarious possibilities in applied remediation engineering and the future of environmental sustainability. Fungi have the biochemical and ecological capability to degrade environmental organic chemicals and to decrease the risk associated with metals, semi-metals, noble metals, and radionuclides, either by chemical modification or by manipulating chemical bioavailability. Additionally, the capability of these fungi to form extended mycelia networks, the low specificity of their catabolic enzymes, and their using pollutants as a growth substrate make these fungi well suited for bioremediation processes. Their mycelia exhibit the robustness of adapting to highly limiting environmental conditions often experienced in the presence of persistent pollutants, which makes them more useful compared to other microbes. However, despite dominating the living biomass in soil and being abundant in aquatic ecosystems, fungi have not been exploited for the bioremediation of such environments. This book covers the various types of fungi and associated fungal processes used to clean up waste and wastewaters in contaminated environments and discusses future potential applications.
Ram Prasad
Ram Prasad is Assistant Professor, Amity Institute of Microbial Technology, Amity University, Uttar Pradesh. He obtained his PhD (Microbiology) from Chaudhary Charan Singh University, Meerut for which he did the experimental work in School of Life Sciences, Jawaharlal Nehru University (JNU), New Delhi. He did his MSc in Life Sciences from School of Life Sciences, JNU, New Delhi and has qualified CSIR-NET, GATE and ASRB-NET. He has seventy-five publications to his credit, which include research papers and book chapters at international and national levels. He also has five patents issued or pending and he is author/editor of three books. Dr Prasad has twelve years of research and nine years of teaching experience. He was awarded Young Scientist Award and Prof JS Datta Munshi Gold Medal. He has also been awarded FSAB fellowship by the Society for Applied Biotechnology in the field of Microbial Biotechnology. Recently, he has been awarded American Cancer Society UICC International Fellowships (2014) for Beginning Investigators and, is presently, Visiting Assistant Professor in Whiting School of Engineering, Department of Mechanical Engineering, Johns Hopkins University, the USA.
Book Currently Unavailable
This book is currently unavailable for publication. We obtained it under a Creative Commons license, but the author or publisher has not granted permission to publish it.
Rate Now
5 Stars
4 Stars
3 Stars
2 Stars
1 Stars
Mycoremediation and Environmental Sustainability: Volume 1 Quotes
Top Rated
Latest
Quate
Be the first to leave a quote and earn 10 points
instead of 3
Comments
Be the first to leave a comment and earn 5 points
instead of 3